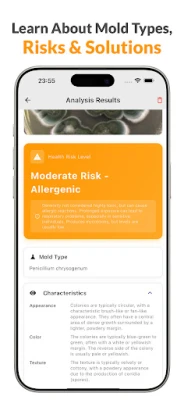
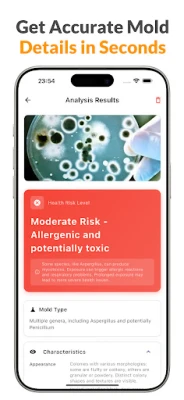

Jaunākā versija
Atjauninājums
martā 01, 2026
martā 01, 2026
Izstrādātājs
CircularX
CircularX
Kategorijas
Izglītība
Izglītība
Platformas
Android
Android
Instalācijas
0
0
Licence
Free
Free
Pakotnes nosaukums
com.circular.moldidentification
com.circular.moldidentification
Ziņot
Ziņot par problēmu
Ziņot par problēmu
Vairāk par Ai Mold identifier
"Ai Mold identifier" ļauj acumirklī identificēt pelējumu, sēnītes un citus izaugumus ar vienkāršu fotoattēlu. Lietotne skenē, analizē un sniedz detalizētu ziņojumu par pelējuma veidu, zinātniskiem datiem un praktiskiem risinājumiem jūsu mājās vai vidē.
Sastopoties ar nezināmu izaugumu mājās, uz sienām, pārtikas vai mēbelēm, ir būtiski rīkoties ātri un zinoši. Lietotne Mold Identifier ir jūsu uzticamais palīgs pelējuma un sēnīšu atpazīšanā, piedāvājot jaudīgus skenēšanas un analīzes rīkus. Vienkārši uzņemiet fotoattēlu, ļaujiet mākslīgajam intelektam veikt analīzi, un dažu sekunžu laikā saņemiet pilnīgu, detalizētu ziņojumu par jebkuru atrasto pelējumu vai sēnīti jūsu apkārtnē. Tā sniedz skaidru izpratni neatkarīgi no tā, vai tā ir parasta pelējums, sēnītes, sporas, miltrasa vai kāds nezināms veidojums.
Katrs Mold Identifier skenējums nodrošina precīzu pelējuma sugas klasifikāciju, atklājot tās zinātnisko nosaukumu un raksturīgās pazīmes. Ziņojumā atradīsiet detalizētu informāciju par pelējuma krāsu, tekstūru, augšanas modeli un sporām, kā arī svarīgus datus par potenciālajiem veselības riskiem un iedarbības līmeņiem. Lietotne sniedz visaptverošas drošības vadlīnijas un ekspertu ieteikumus par alerģijām, elpceļu problēmām un to, kad ir nepieciešams profesionāļa apmeklējums, nodrošinot jūsu un jūsu ģimenes labklājību.
Ne tikai identificējiet, bet arī rīkojieties! Mold Identifier piedāvā praktiskus DIY risinājumus pelējuma likvidēšanai, tostarp soli pa solim tīrīšanas rokasgrāmatas, drošus mājas līdzekļus un profilakses padomus. Jūs atradīsiet arī ieteikumus par piemērotiem produktiem un instrumentiem. Visi jūsu skenējumi tiek saglabāti, ļaujot jums viegli organizēt atklājumus, pievienot piezīmes un salīdzināt iepriekšējos rezultātus, lai uzraudzītu pelējuma izplatību. Mold Identifier ir neaizstājams instruments mājas īpašniekiem, īrniekiem, dārzniekiem un ikvienam, kurš vēlas nodrošināt veselīgu un drošu vidi sev apkārt, atpazīstot visdažādākos sēnīšu veidus – no melnā pelējuma līdz sēnēm ārpus telpām.
Katrs Mold Identifier skenējums nodrošina precīzu pelējuma sugas klasifikāciju, atklājot tās zinātnisko nosaukumu un raksturīgās pazīmes. Ziņojumā atradīsiet detalizētu informāciju par pelējuma krāsu, tekstūru, augšanas modeli un sporām, kā arī svarīgus datus par potenciālajiem veselības riskiem un iedarbības līmeņiem. Lietotne sniedz visaptverošas drošības vadlīnijas un ekspertu ieteikumus par alerģijām, elpceļu problēmām un to, kad ir nepieciešams profesionāļa apmeklējums, nodrošinot jūsu un jūsu ģimenes labklājību.
Ne tikai identificējiet, bet arī rīkojieties! Mold Identifier piedāvā praktiskus DIY risinājumus pelējuma likvidēšanai, tostarp soli pa solim tīrīšanas rokasgrāmatas, drošus mājas līdzekļus un profilakses padomus. Jūs atradīsiet arī ieteikumus par piemērotiem produktiem un instrumentiem. Visi jūsu skenējumi tiek saglabāti, ļaujot jums viegli organizēt atklājumus, pievienot piezīmes un salīdzināt iepriekšējos rezultātus, lai uzraudzītu pelējuma izplatību. Mold Identifier ir neaizstājams instruments mājas īpašniekiem, īrniekiem, dārzniekiem un ikvienam, kurš vēlas nodrošināt veselīgu un drošu vidi sev apkārt, atpazīstot visdažādākos sēnīšu veidus – no melnā pelējuma līdz sēnēm ārpus telpām.
Novērtēt lietotni
Pievienot komentāru un atsauksmi
Lietotāju atsauksmes
Balstīts uz 0 atsauksmēm
Vēl nav pievienota neviena atsauksme.
Komentāri netiks apstiprināti publicēšanai, ja tie ir surogātpasts, aizskaroši, neatbilst tēmai, satur lamuvārdus, personiskus uzbrukumus vai veicina jebkāda veida naidu.
Vairāk »










Populāras lietotnes

Bookshelf-Your virtual librarySquidBit

Elpošanas vingrinājumiATA App

Listă de Cumpărături și OferteDaniLex Soft

Find Level: Bubble, Laser ToolVasundhara Infotech LLC

Idle : Mold FarmPond studio

TAMM - Abu Dhabi GovernmentDepartment of Government Enablement

Bubble level for androidIDAFN Technology

Antique Identifier - AntiquebyPixoby OU

AIMPArtem Izmaylov

Zvejas MezgliFISH PLANET APPS